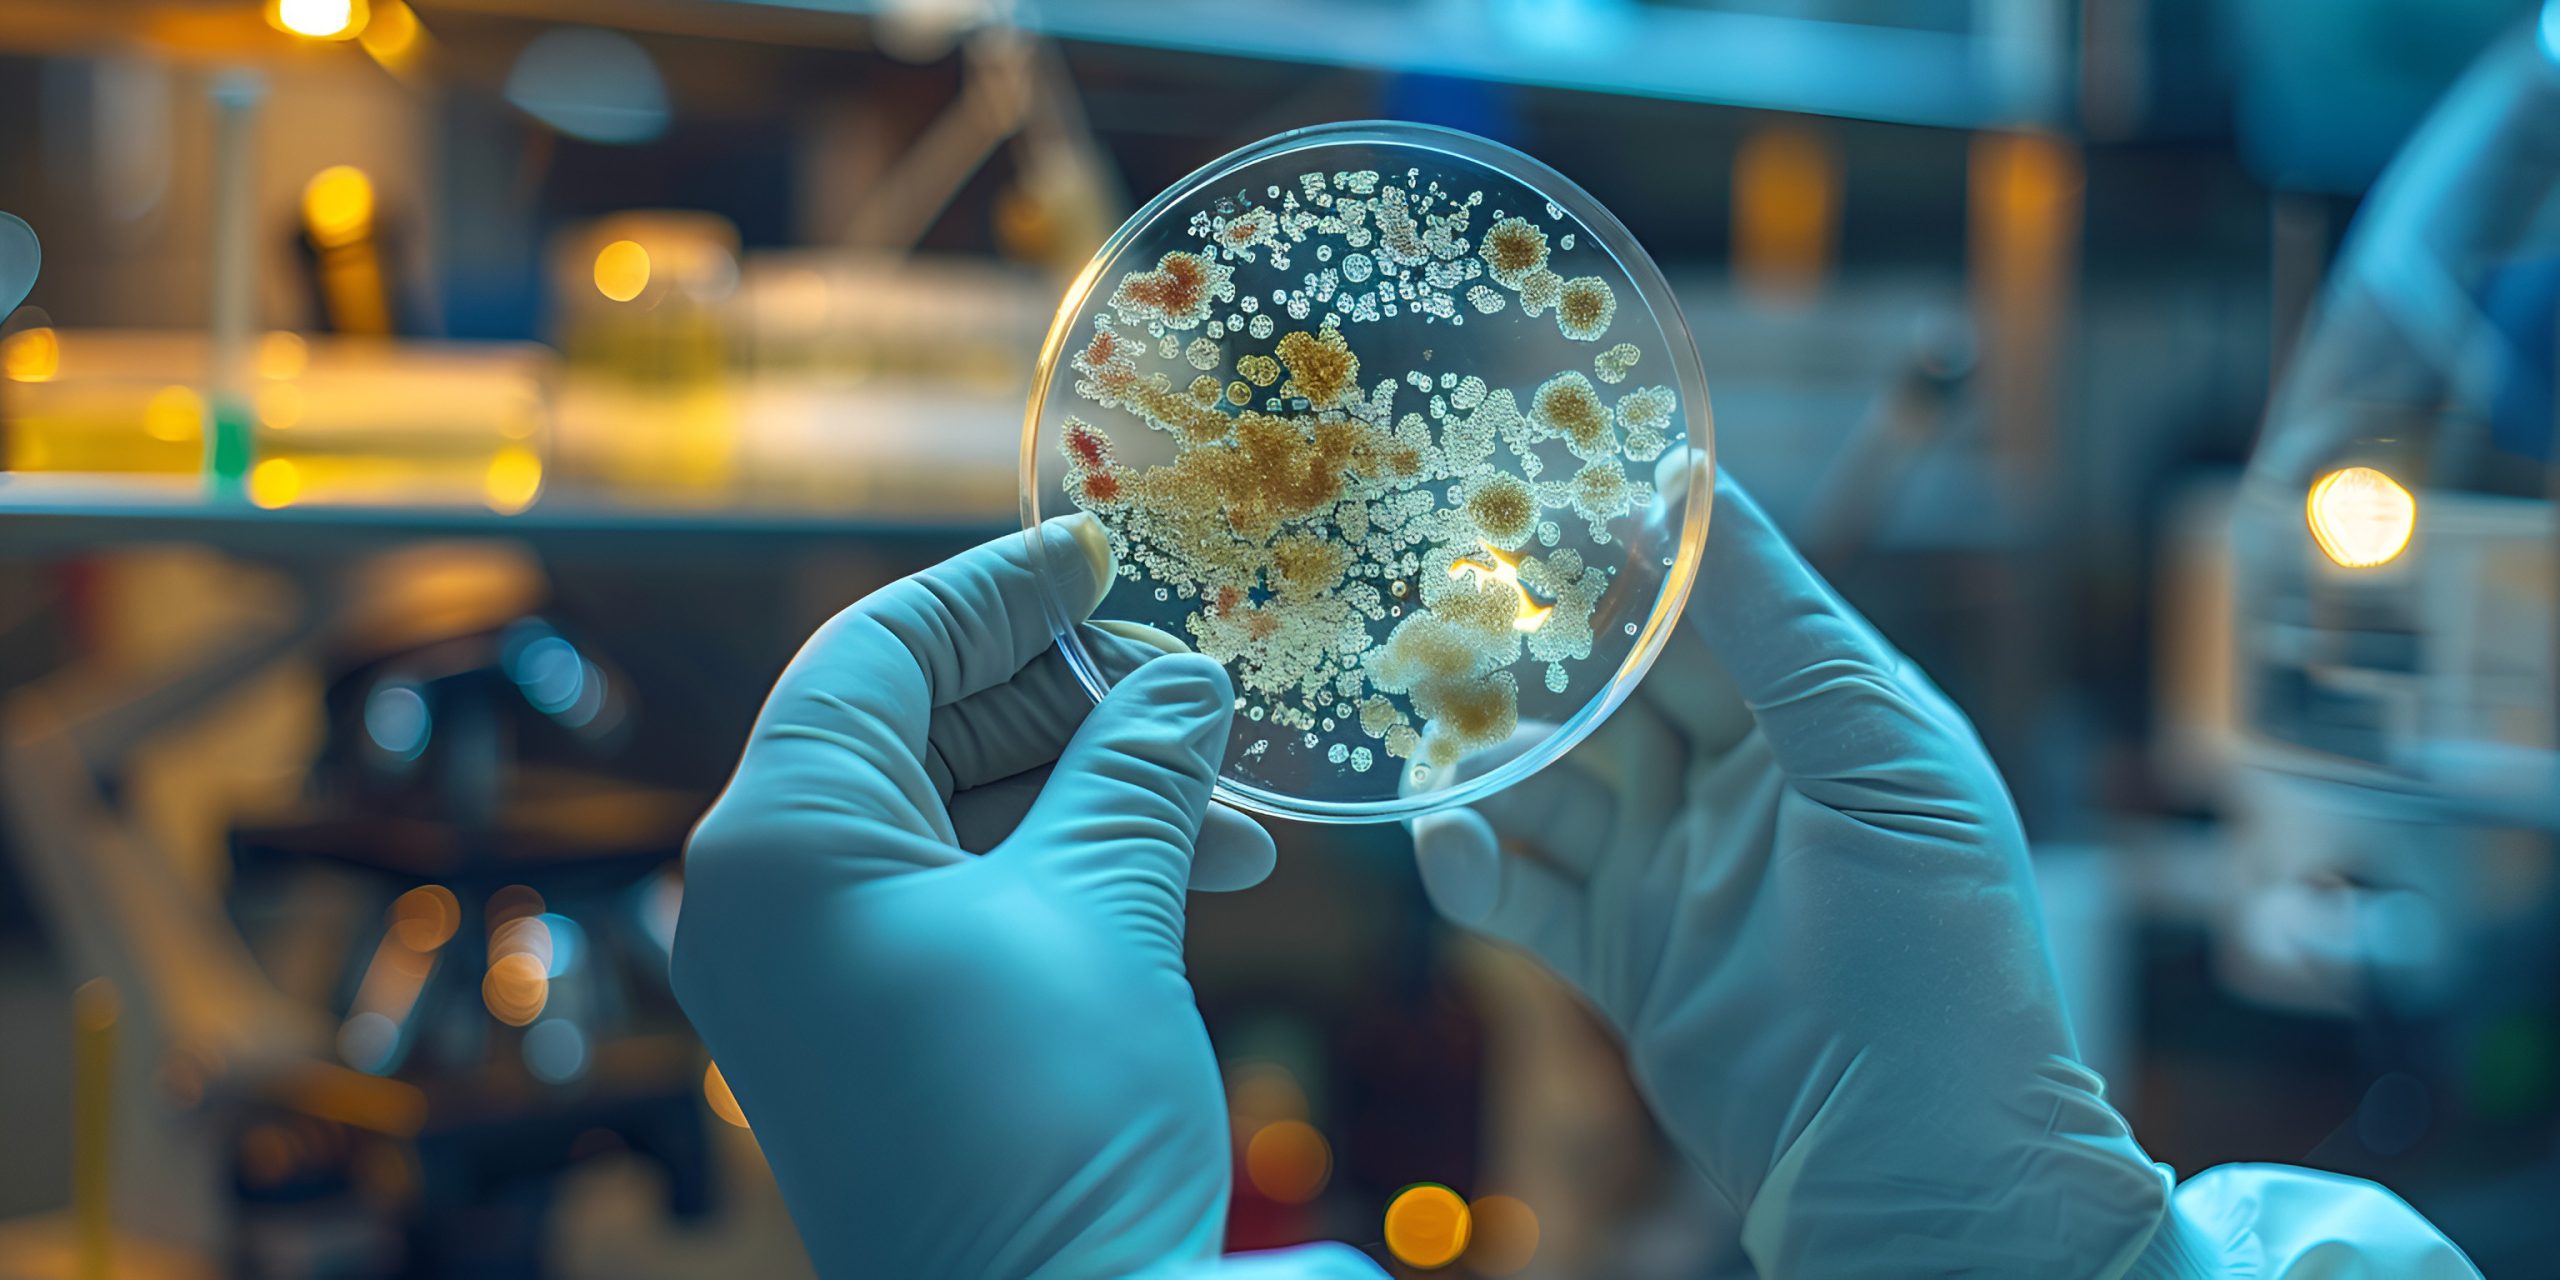
LABORATORY

UV Disinfection
log1 to log7
UV Disinfection describes the treatment of air, surfaces or liquids using short-wave UVC radiation. Thanks to its cell-damaging effect, it represents an effective and chemical-free alternative to conventional disinfection methods.
UV-C technology inactivates microorganisms such as bacteria, viruses, yeasts, and fungi and is therefore relevant in a wide range of applications where reliable germ reduction is required.
For example, companies in the food industry use UV systems to minimize contamination and extend the shelf life of products. Beyond that, UV treatment plays a key role in many sectors, as it can significantly reduce or even completely replace the need for chemicals. This applies not only to water treatment but also to air disinfection and surface hygiene.
UV components and systems thus enable efficient germ reduction and can even create aseptic environments.
Without the use of chemicals
our expertise in uv solutions

UV-COMPONENTS
High-quality, customized UV components designed to integrate seamlessly into your processes
Contact And Support
Do you have any questions or need support? We are happy to help you.
What is UV-C Radiation?
UV-C radiation is part of natural sunlight and a powerful tool against microorganisms. It works physically by disrupting the DNA or RNA of bacteria, viruses, and molds, preventing them from reproducing.

Why this matters for you
- Chemical-free & residue-free – safe for products and the environment
- Effective & reliable – protects your processes from contamination
- Versatile – applicable for air, surfaces, water, and odor reduction
How UV-C Disinfection works
UV-C offers fast, safe, and sustainable protection across your operations:
-
Kills Microorganisms – stops bacteria, viruses, and molds from spreading
-
No Chemicals or Residues – purely physical process
-
Proven & Reliable – used worldwide in food, water, air, and laboratory applications
Choose the right UV-C Technology
Hoenle provides solutions across the full UV spectrum, tailored to your needs:
-
Low Pressure (LP) – precise, efficient germicidal effect at 254 nm for controlled applications
-
Medium Pressure (MP) – high-intensity, broad-spectrum UV for fast treatment of large volumes
-
Pulsed Light (PL) – short, high-energy pulses for rapid surface and material disinfection
Your benefit: the optimal technology for your application, validated and safe.
Applications that deliver real benefits
-
Air Disinfection – reduce airborne pathogens and improve indoor air quality
-
Surface Disinfection – maintain hygienic, safe surfaces
-
Water Purification – ensure pathogen-free water for operations or production
-
Odor Elimination – efficiently remove odors caused by bacteria or materials
-
Room Air Drying – support hygiene and operational efficiency in sensitive environments
-
Components & Custom Solutions – high-quality UV modules integrated seamlessly into your processes
-
Laboratory Services – expert testing, validation, and process optimization to ensure reliable results
Customer Benefit: maximum hygiene, safe products, operational efficiency, and peace of mind.
FAQ's
UV-C radiation - the shortest wavelenghts with maximum effect
UV-C light covers the shortest ultraviolet range (100–280 nm). Thanks to the intact ozone layer, this high-energy radiation is naturally filtered and does not reach the Earth’s surface.
Unlike UV-B, which penetrates deeply into the skin, no proven causal link between UV-C exposure and skin cancer has been found. Still, UV-C must always be applied under controlled conditions for safety.
The dose principle: Time x Intensity = Effectiveness
The effectiveness of UV-C disinfection depends on two factors: exposure time and light intensity. The product of both is expressed as mWs/cm².
Microorganisms with simple structures (e.g. bacteria) can be deactivated with a low dose, while more complex organisms such as fungi and spores require higher energy levels.
Your benefit: By adjusting the UV dose, you gain full control over disinfection performance – tailored exactly to your process needs.
Safe, reliable & chemical-free?
Hoenle UV-C lamps operate mainly at 254 nm and 185 nm – except for pulsed light. For food applications, only ozone-free emitters are used to guarantee safe and residue-free disinfection.
A major advantage of UV-C disinfection: microorganisms cannot develop resistance. It remains effective even when bacteria or viruses are resistant to alcohol, antibiotics, or other conventional methods.
Your benefit: With decades of expertise, reliable technology, and proven UV-C dosing, you can achieve consistent results – whether against E. coli, SARS, Legionella, or mold.
UV-C technology is scientifically validated and recognized in international standards:
-
Water disinfection: Certified according to DVGW and Austrian Standard
-
Air handling systems: Regulated by VDI 6022

Is UV-C safe for my team?
Yes – Hoenle solutions are designed with shielding and automated controls to protect people while disinfecting effectively.
Will UV-C affect my products?
No – UV-C is purely physical and leaves no chemical residues or taste.
Can microorganisms develop resistance to UV-C?
No – the physical action of UV-C prevents any resistance from developing.
Where can UV-C be applied?
Air, surfaces, water and odor management – wherever hygiene is critical.
How do I choose the right UV-C technology?
Our experts guide you: Low Pressure for precision, Medium Pressure for high-intensity and Pulsed Light for fast surface treatment.